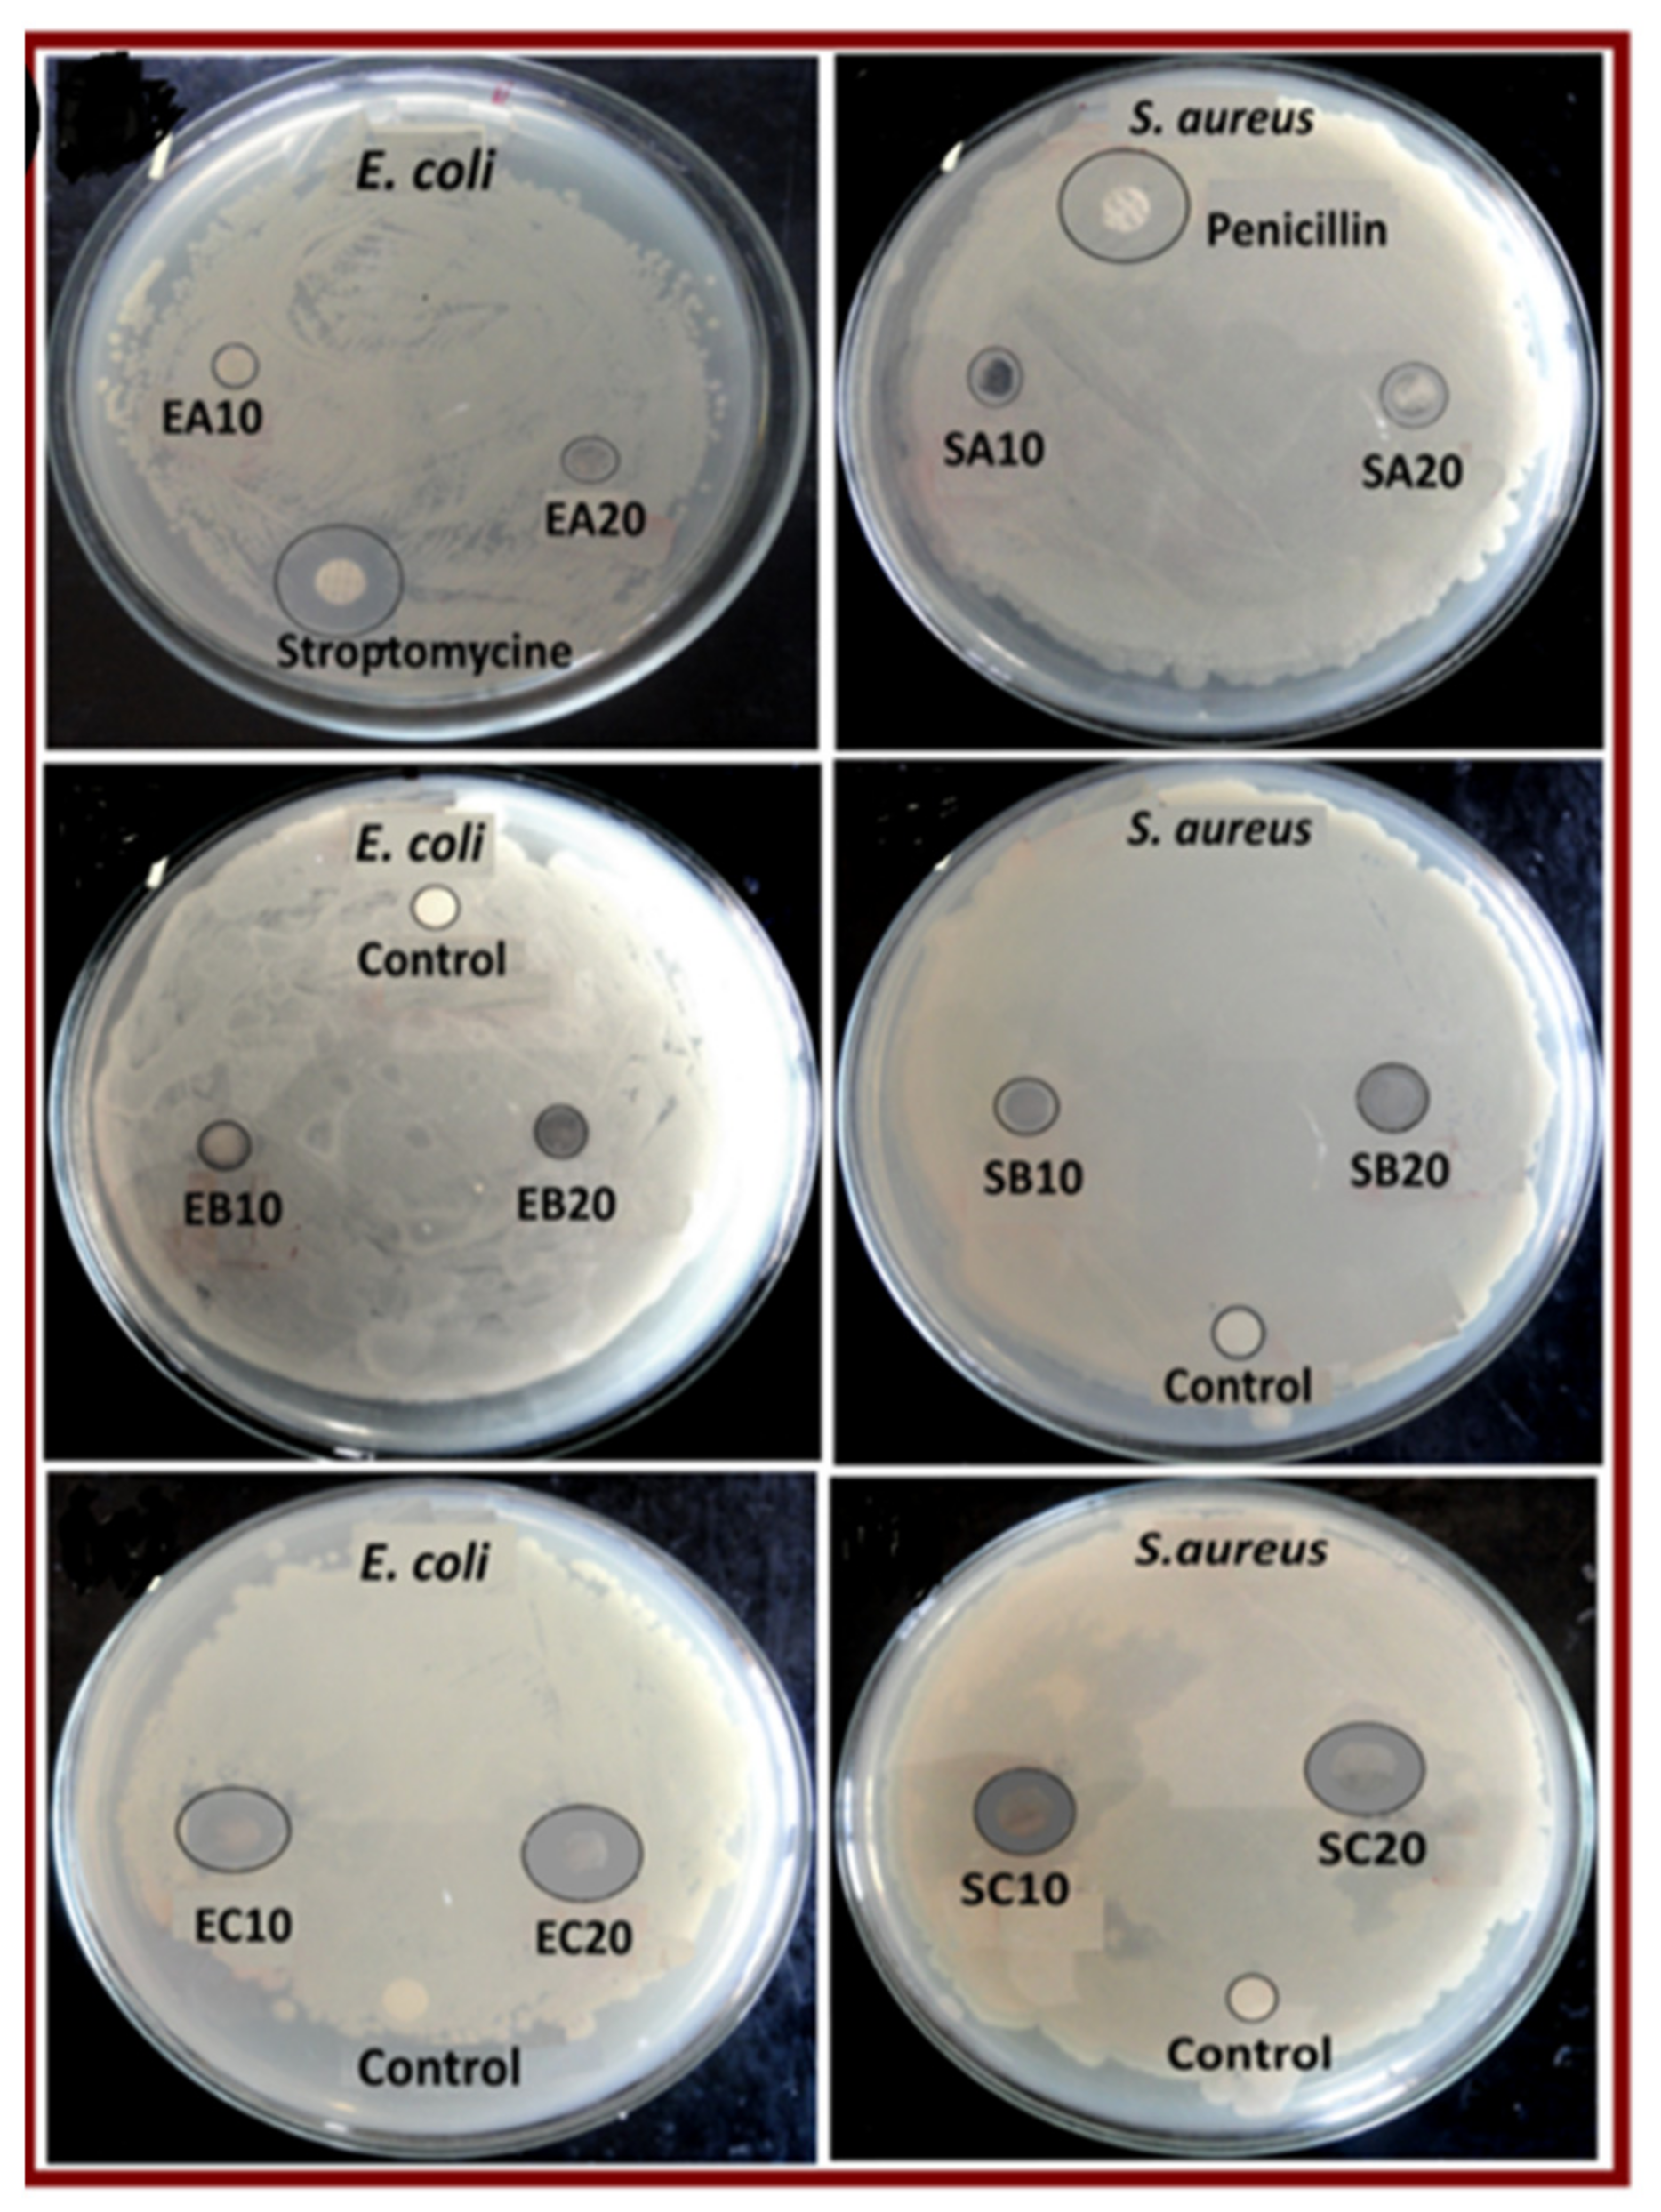
Macromol 02 00005 g005

Antimicrobial Activities of Conducting Polymers and Their Composites
Abstract
:1. Introduction
2. Polypyrrole (PPY) Based Composites for Antibacterial Activity
- -
- Form covalent bonds with S (e.g., thiol of glutathione) to deplete this antioxidant reserve [66].
- -
- Metal ions or their complexes can replace original metals present in biomolecules leading to cellular dysfunction [67], known as ionic mimicry or molecular mimicry. A known target is the Fe–S clusters of bacterial dehydratases that are particularly vulnerable to site-specific inactivation by toxic metals [68].
- -
- Cupric ions (Cu2+) can form organic complexes with bacterial S, N, or O-containing functional groups to affect the conformational structure of nucleic acids and proteins by oxidative phosphorylation and osmotic balance.
- -
- Upregulate genes involved in the elimination of ROS-generating oxidative stress [66].
3. Polyaniline (PANI) for Metal/Metal Oxides-Based Composites
4. Polyaniline (PANI) for Carbon Material-Based Composites
5. Antimicrobial Mechanisms
6. Cytotoxicity Aspects and Antimicrobial Mechanisms
7. Future Studies and Endeavors
- -
- A complete list of priority pathogens. They must be tested against several pathogens, which are capable of “escaping” from common antibacterial treatments and have been listed as the World Health Organization (WHO) priority pathogens [110]: Enterococcus faecium, Staphylococcus aureus, Klebsiella pneumoniae, Acinetobacter baumannii, Pseudomonas aeruginosa, and Enterobacter spp. Of importance is the eradication of A. baumnannii, which has been reported to be resistant to most known antibiotics, even colistin, the last resort of antibiotics. Besides its outer membrane being relatively impermeable, this bacterium is equipped with efflux pumps and produces beta-lactamases and biofilms to render multiple drugs ineffective. K. pneumoniae has developed resistance to almost all available antibiotics: fluoroquinolones, third-generation cephalosporins, and aminoglycosides. Enterobacter spp. and P. aeruginosa have become resistant to cephalosporins and carbapenems. Enterococcus faecium and E. faecalis have most frequently infected humans. Considering the emergence of multidrug-resistant bacteria and the lack of novel antibiotics, some discontinued toxic agents, e.g., colistin (polymyxin E), are recycled as the last “silver bullet” to kill multidrug-resistant bacteria [111]. Unfortunately, colistin-resistant bacteria have also emerged [112,113].
- -
- Biodegradable. Controlled degradation of antimicrobial polymers is another prerequisite considering their plausible prolonged toxicity in human bodies or environments.
- -
- Hemolysis. For treatment, conducting polymers must have low toxicity toward human erythrocytes with <4% hemolysis at the given MIC as a guideline as mentioned previously [98].
- -
- Competing technologies. Dendrimers exhibit antimicrobial activities as they cause destabilization of the bacterial membrane structure. Dendrimers with multi-functional groups can be conjugated with existing antibiotics or peptides to augment their antimicrobial activities. An example is the antimicrobial activities of peptide dendrimer against multidrug-resistant Acinetobactor baumanii and P. aeruginosa [114]. Bacterial cellulose can be loaded with AgNPs for wound healing treatment [115]. Carboxylated nanocrystalline cellulose can be easily functionalized and decorated with AuNPs [116] as a platform for developing antimicrobial nanocomposites. A composite of chitosan-AuNPs shows high antibacterial activities with low cytotoxicity [117]. The surface of AuNPs can be functionalized with antimicrobial molecules, e.g., 6-aminopenicillanic acid [118]. Albeit gold spheres are commonly used, gold rods and gold nanoparticles with other geometries remain to be tested [119].
8. Conclusions
Author Contributions
Funding
Institutional Review Board Statement
Informed Consent Statement
Data Availability Statement
Conflicts of Interest
References
- Kapoor, G.; Saigal, S.; Elongavan, A. Action and resistance mechanisms of antibiotics: A guide for clinicians. J. Anaesthesiol. Clin. Pharmacol. 2017, 33, 300–305. [Google Scholar] [CrossRef]
- Yoneyama, H.; Katsumata, R. Antibiotic resistance in bacteria and its future for novel antibiotic development. Biosci. Biotechnol. Biochem. 2006, 70, 1060–1075. [Google Scholar] [CrossRef]
- Fisher, J.F.; Meroueh, S.O.; Mobashery, S. Bacterial resistance to β-lactam antibiotics: compelling opportunism, compelling opportunity. Chem. Rev. 2005, 105, 395–442. [Google Scholar] [CrossRef] [PubMed]
- Reynolds, P.E. Structure, biochemistry and mechanism of action of glycopeptide antibiotics. Eur. J. Clin. Microbiol. Infect. Dis. 1989, 8, 943–950. [Google Scholar] [CrossRef] [PubMed]
- Delcour, A.H. Outer membrane permeability and antibiotic resistance. Biochim. Biophys. Acta 2009, 1794, 808–816. [Google Scholar] [CrossRef] [Green Version]
- Bush, K.; Bradford, P.A. β-lactams and β-lactamase inhibitors: An overview. Cold Spring Harb. Perspect. Med. 2016, 6, a025247. [Google Scholar] [CrossRef] [PubMed]
- Nikaido, H. Molecular basis of bacterial outer membrane permeability revisited. Microbiol. Mol. Biol. Rev. 2003, 67, 593–656. [Google Scholar] [CrossRef] [Green Version]
- Haupt, I.; Hubener, R.; Thrum, H. Streptothricin F, an inhibitor of protein synthesis with miscoding activity. J. Antibiot. 1978, 31, 1137–1142. [Google Scholar] [CrossRef] [PubMed] [Green Version]
- Zahringer, U.; Voigt, W.; Seltmann, G. Nourseothricin (streptothricin) inactivated by a plasmid pIE636 encoded acetyltransferase of Escherichia coli: Location of the acetyl group. FEMS Microbiol. Lett. 1993, 110, 331–334. [Google Scholar] [CrossRef]
- Faron, M.L.; Ledeboer, N.A.; Buchan, B.W. Resistance mechanisms, epidemiology, and approaches to screening for vancomycin-resistant enterococcus in the health care setting. J. Clin. Microbiol. 2016, 54, 2436–2447. [Google Scholar] [CrossRef] [Green Version]
- Soto, S.M. Role of efflux pumps in the antibiotic resistance of bacteria embedded in a biofilm. Virulence 2013, 4, 223–229. [Google Scholar] [CrossRef] [PubMed] [Green Version]
- Lee, A.; Mao, W.; Warren, M.S.; Mistry, A.; Hoshino, K.; Okumura, R.; Ishida, H.; Lomovskaya, O. Interplay between efflux pumps may provide either additive or multiplicative effects on drug resistance. J. Bacteriol. 2000, 182, 3142–3150. [Google Scholar] [CrossRef] [PubMed] [Green Version]
- Sharma, D.; Misba, L.; Khan, A.U. Antibiotics versus biofilm: An emerging battleground in microbial communities. Antimicrob. Resist. Infect. Control 2019, 8, 76. [Google Scholar] [CrossRef]
- Chougule, M.A.; Arts, A.R.; Godse, P.; Sen, S. Synthesis and characterization of polypyrrole (PPy) thin films. Soft Nanosci. Lett. 2011, 1, 6–10. [Google Scholar] [CrossRef] [Green Version]
- Sevilla, F. Chemical sensors based on conducting polymers. In Proceedings of the Asian Conference on Sensors, Kebangsann, Malaysia, 18 July 2003; pp. 87–92. [Google Scholar]
- Guimard, N.K.; Gomez, N.; Schmidt, C.E. Conducting polymers in biomedical engineering. Prog. Polym. Sci. 2007, 32, 876–921. [Google Scholar] [CrossRef]
- Spitalsky, Z.; Tasis, D.; Papagelis, K.; Galiotis, C. Carbon nanotube–polymer composites: Chemistry, processing, mechanical and electrical properties. Prog. Polym. Sci. 2010, 35, 357–401. [Google Scholar] [CrossRef]
- Park, K.-S.; Schougaard, S.B.; Goodenough, J.B. Conducting-polymer/iron-redox- couple composite cathodes for lithium secondary batteries. Adv. Mater. 2007, 19, 848–851. [Google Scholar] [CrossRef]
- Kang, H.; Geckeler, K. Enhanced electrical conductivity of polypyrrole prepared by chemical oxidative polymerization: Effect of the preparation technique and polymer additive. Polymer 2000, 41, 6931–6934. [Google Scholar] [CrossRef]
- Li, J.; Zhang, Q.; Feng, J.; Yan, W. Synthesis of PPy-modified TiO2 composite in H2SO4 solution and its novel adsorption characteristics for organic dyes. Chem. Eng. J. 2013, 225, 766–775. [Google Scholar] [CrossRef]
- Ebrahimiasl, S.; Zakaria, A.; Kassim, A.; Basri, S.N. Novel conductive polypyrrole/zinc oxide/chitosan bionanocomposite: Synthesis, characterization, antioxidant, and antibacterial activities. Int. J. Nanomed. 2015, 10, 217. [Google Scholar] [CrossRef] [Green Version]
- Moorthy, M.; Kumar, V.B.; Porat, Z.; Gedanken, A. Novel polymerization of aniline and pyrrole by carbon dots. New J. Chem. 2018, 42, 535–540. [Google Scholar] [CrossRef]
- Maruthapandi, M.; Kumar, V.B.; Gedanken, A. Carbon dot initiated synthesis of poly(4,4′-diaminodiphenylmethane) and its methylene blue adsorption. ACS Omega 2018, 3, 7061–7068. [Google Scholar] [CrossRef] [PubMed]
- Maruthapandi, M.; Luong, J.H.T.; Gedanken, A. Kinetic, isotherm and mechanism studies of organic dye adsorption on poly(4,40-oxybisbenzenamine) and copolymer of poly(4,40-oxybisbenzenamine-pyrrole) macro-nanoparticles synthesized by multifunctional carbon dots. New J. Chem. 2019, 43, 1926–1935. [Google Scholar] [CrossRef]
- Maruthapandi, M.; Kumar, V.B.; Luong, J.H.T.; Gedanken, A. Kinetics, isotherm, and thermodynamic studies of methylene blue adsorption on polyaniline and polypyrrole macro-nanoparticles synthesized by C-dot-initiated polymerization. ACS Omega 2018, 3, 7196–7203. [Google Scholar] [CrossRef] [PubMed]
- Maruthapandi, M.; Nagvenkar, A.P.; Perelshtein, I.; Gedanken, A. Carbon-dot initiated synthesis of polypyrrole and polypyrrole@CuO micro/nanoparticles with enhanced antibacterial activity. ACS Appl. Polym. Mater. 2019, 1, 1181–1186. [Google Scholar] [CrossRef]
- Sadki, S.; Schottland, P.; Sabouraud, G.; Brodie, N. The mechanisms of pyrrole electropolymerization. Chem. Soc. Rev. 2000, 29, 283–293. [Google Scholar]
- Liu, F.; Yuan, Y.; Li, L.; Shang, S.; Yu, X.; Zhang, Q.; Jiang, S.; Wu, Y. Synthesis of polypyrrole nanocomposites decorated with silver nanoparticles with electrocatalysis and antibacterial property. Compos. Part B Eng. 2015, 69, 232–236. [Google Scholar] [CrossRef]
- Zhou, J.; Lü, Q.F.; Luo, J.J. Efficient removal of organic dyes from aqueous solution by rapid adsorption onto polypyrrole–based composites. J. Clean. Prod. 2018, 167, 739–748. [Google Scholar] [CrossRef]
- Saafan, S.A. Study of dielectric properties of polypyrrole prepared using two different oxidizing agents. J. Appl. Poly. Sci. 2005, 99, 3370–3379. [Google Scholar] [CrossRef]
- Lee, J.Y.; Kim, D.Y.; Kim, C.Y. Synthesis of soluble polypyrrole of the doped state in organic solvents. Synth. Met. 1995, 74, 103–106. [Google Scholar] [CrossRef]
- Halder, S.; Yadav, K.K.; Sarkar, R.; Mukherjee, S.; Saha, P.; Haldar, S.; Karmakar, S.; Sen, T. Alteration of Zeta potential and membrane permeability in bacteria: A study with cationic agents. SpringerPlus 2014, 4, 672. [Google Scholar] [CrossRef] [PubMed] [Green Version]
- Liang, X.; Liao, C.; Thompson, M.L.; Soupir, M.L.; Jarboe, L.R.; Dixon, P.M. E. coli surface properties differ between stream water and sediment environments. Front. Microbiol. 2016, 7, 1732. [Google Scholar] [CrossRef] [PubMed] [Green Version]
- Zhang, X.; Bai, R. Surface electric properties of polypyrrole in aqueous solutions. Langmuir 2003, 19, 10703–10709. [Google Scholar] [CrossRef]
- Oh, E.J.; Jang, K.S.; MacDiarmid, A.G. High molecular weight soluble polypyrrole. Synth. Met. 2001, 125, 267–272. [Google Scholar] [CrossRef]
- Murugesan, B.; Pandiyan, N.; Arumugam, M.; Sonamuthu, J.; Samayanan, S.; Yurong, C.; Juming, Y.; Mahalingam, S. Fabrication of palladium nanoparticles anchored polypyrrole functionalized reduced graphene oxide nanocomposite for antibiofilm associated orthopedic tissue engineering. Appl. Surf. Sci. 2020, 510, 145403. [Google Scholar] [CrossRef]
- Murugesan, B.; Sonamuthu, J.; Samayanan, S.; Arumugam, S.; Mahalingam, S. Highly biological active antibiofilm, anticancer and osteoblast adhesion efficacy from MWCNT/PPy/Pd nanocomposite. Appl. Surf. Sci. 2018, 434, 400–411. [Google Scholar] [CrossRef]
- Anitha, B.; Vibitha, B.V.; Jyothy, P.S.P.; Tharay, N. Development of conducting polypyrrole nanocomposites for antimicrobial applications. AIP Conf. Proc. 2020, 2224, 080002. [Google Scholar]
- Ramirez, D.O.S.; Varesano, A.; Carletto, R.A.; Vineis, C.; Perelshtein, I.; Natan, M.; Perkas, N.; Banin, E.; Gedanken, A. Antibacterial properties of polypyrrole-treated fabrics by ultrasound deposition. Mater. Sci. Eng. C 2019, 102, 164–170. [Google Scholar] [CrossRef]
- Vala, A.; Shah, S. Rapid synthesis of silver nanoparticles by a marine-derived fungus Aspergillus niger and their antimicrobial potentials. Int. J. Nanosci. Nanotechnol. 2012, 8, 197–206. [Google Scholar]
- Guo, N.; Cang, F.; Wang, Z.; Zhao, T.T.; Song, X.R.; Farris, S.; Li, Y.Y.; Fu, Y.J. Magnetism and NIR dual-response polypyrrole-coated Fe3O4 nanoparticles for bacteria removal and inactivation. Mater. Sci. Eng. C 2021, 126, 112143. [Google Scholar] [CrossRef]
- Zasońska, B.A.; Acharya, U.; Pfleger, J.; Humpolíček, P.; Vajďák, J.; Svoboda, J.; Petrovsky, E.; Hromádková, J.; Walterová, Z.; Bober, P. Multifunctional polypyrrole@ maghemite@ silver composites: Synthesis, physicochemical characterization and antibacterial properties. Chem. Pap. 2018, 72, 1789–1797. [Google Scholar] [CrossRef]
- Jlassi, K.; Sliem, M.H.; Benslimane, F.M.; Eltai, N.O.; Abdullah, A.M. Design of hybrid clay/polypyrrole decorated with silver and zinc oxide nanoparticles for anticorrosive and antibacterial applications. Prog. Org. Coat. 2020, 149, 105918. [Google Scholar] [CrossRef]
- Ahmad, N.; Sultana, S.; Faisal, S.M.; Ahmed, A.; Sabir, S.; Khan, M.Z. Zinc oxide-decorated polypyrrole/chitosan bionanocomposites with enhanced photocatalytic, antibacterial and anticancer performance. RSC Adv. 2019, 9, 41135–41150. [Google Scholar] [CrossRef] [Green Version]
- Maruthapandi, M.; Saravanan, A.; Luong, J.H.T.; Gedanken, A. Antimicrobial properties of polyaniline and polypyrrole decorated with zinc-doped copper oxide microparticles. Polymers 2020, 12, 1286. [Google Scholar] [CrossRef]
- Singh, A.; Goswami, A.; Nain, S. Enhanced antibacterial activity and photo-remediation of toxic dyes using Ag/SWCNT/PPy based nanocomposite with core–shell structure. Appl. Nanosci. 2020, 10, 2255–2268. [Google Scholar] [CrossRef]
- Liu, C.; Chen, F.Y.; Tang, Y.B.; Huo, P.W. An environmentally friendly nanocomposite polypyrrole@ silver/reduced graphene oxide with high catalytic activity for bacteria and antibiotics. J. Mater. 2021, 32, 15211–15225. [Google Scholar] [CrossRef]
- Du, H.; Parit, M.; Liu, K.; Zhang, M.; Jiang, Z.; Huang, T.S.; Zhang, X.; Si, C. Multifunctional cellulose nanopaper with superior water-resistant, conductive, and antibacterial properties functionalized with chitosan and polypyrrole. ACS Appl. Mater. Interfaces 2021, 13, 32115–32125. [Google Scholar] [CrossRef]
- Soleimani, M.; Ghorbani, M.; Salahi, S. Antibacterial activity of polypyrrole-chitosan nanocomposite: Mechanism of action. Int. J. Nanosci. Nanotechnol. 2016, 12, 191–197. [Google Scholar]
- Zare, E.N.; Lakouraj, M.M.; Mohseni, M. Biodegradable polypyrrole/dextrin conductive nanocomposite: Synthesis, characterization, antioxidant and antibacterial activity. Synth. Met. 2014, 187, 9–16. [Google Scholar] [CrossRef]
- Zhang, Q.; Qiao, Y.; Zhu, J.; Li, Y.; Li, C.; Lin, J.; Li, X.; Han, H.; Mao, J.; Wang, F.; et al. Electroactive and antibacterial surgical sutures based on chitosan-gelatin/tannic acid/polypyrrole composite coating. Compos. Part B Eng. 2021, 223, 109140. [Google Scholar] [CrossRef]
- Milakin, K.A.; Capáková, Z.; Acharya, U.; Vajďák, J.; Morávková, Z.; Hodan, J.; Humpolíček, P.; Bober, P. Biocompatible and antibacterial gelatin-based polypyrrole cryogels. Polymer 2020, 197, 122491. [Google Scholar] [CrossRef]
- Parit, M.; Du, H.; Zhang, X.; Prather, C.; Adams, M.; Jiang, Z. Polypyrrole and cellulose nanofiber based composite films with improved physical and electrical properties for electromagnetic shielding applications. Carbohydr. Polym. 2020, 240, 116304. [Google Scholar] [CrossRef] [PubMed]
- Hasantabar, V.; Lakouraj, M.M.; Zare, E.N.; Mohseni, M. Innovative magnetic tri-layered nanocomposites based on polyxanthone triazole, polypyrrole and iron oxide: Synthesis, characterization and investigation of the biological activities. RSC Adv. 2015, 5, 70186–70196. [Google Scholar] [CrossRef]
- Center for Disease Control. Healthcare Associated Infection Progress Report. CDC. 2014. Available online: https://www.cdc.gov/hai/surveillance/progress-report/index.html (accessed on 5 July 2018).
- Stejskal, J.; Trchová, M.; Kasparyan, H.; Kopecky, D.; Kolska, Z.; Prokes, J.; Krivka, I.; Vajdak, J.; Humpolicek, P. Pressure-sensitive conducting and antibacterial materials obtained by in situ dispersion coating of macroporous melamine sponges with polypyrrole. ACS Omega 2021, 6, 20895–20901. [Google Scholar] [CrossRef] [PubMed]
- Xu, Y.; Ma, J.; Han, Y.; Xu, H.; Wang, Y.; Qi, D.; Wang, W. A simple and universal strategy to deposit Ag/polypyrrole on various substrates for enhanced interfacial solar evaporation and antibacterial activity. Chem. Eng. J. 2020, 384, 123379. [Google Scholar] [CrossRef]
- Das, K.K.; Patnaik, S.; Mansingh, S.; Behera, A.; Mohanty, A.; Acharya, C.; Parida, K.M. Enhanced photocatalytic activities of polypyrrole sensitized zinc ferrite/graphitic carbon nitride n-n heterojunction towards ciprofloxacin degradation, hydrogen evolution and antibacterial studies. J. Colloid Interface Sci. 2020, 561, 551–567. [Google Scholar] [CrossRef]
- Bideau, B.; Bras, J.; Saini, S.; Daneault, C.; Loranger, E. Mechanical and antibacterial properties of a nanocellulose-polypyrrole multilayer composite. Mater. Sci. Eng. C 2016, 69, 977–984. [Google Scholar] [CrossRef]
- Guo, L.; Ren, S.; Qiu, T.; Wang, L.; Zhang, J.; He, L.; Li, X. Synthesis of polystyrene@(silver–polypyrrole) core/shell nanocomposite microspheres and study on their antibacterial activities. J. Nanopart. Res. 2015, 17, 47. [Google Scholar] [CrossRef]
- Palza, H. Antimicrobial polymers with metal nanoparticles. Int. J. Mol. Sci. 2015, 16, 2099–2116. [Google Scholar] [CrossRef] [Green Version]
- Mathews, S.; Hans, M.; Mücklich, F.; Solioz, M. Contact killing of bacteria on copper is suppressed if bacterial-metal contact is prevented and is induced on iron by copper ions. Appl. Environ. Microbiol. 2013, 79, 2605–2611. [Google Scholar] [CrossRef] [Green Version]
- Prabhu, S.; Poulose, E.K. Silver nanoparticles: Mechanism of antimicrobial action, synthesis, medical applications, and toxicity effects. Int. Nano Lett. 2012, 2, 32. [Google Scholar] [CrossRef] [Green Version]
- Bremner, I. Manifestations of copper excess. Am. J. Clin. Nutr. 1998, 67, 1069S–1073S. [Google Scholar] [CrossRef]
- Buettner, G.R.; Jurkiewicz, B.A. Catalytic metals, ascorbate and free radicals: Combinations to avoid. Radiat. Res. 1996, 145, 532–541. [Google Scholar] [CrossRef] [PubMed] [Green Version]
- Lemire, J.A.; Harrison, J.J.; Turner, R.J. Antimicrobial activity of metals: Mechanisms, molecular targets and applications. Nat. Rev. Microbiol. 2013, 11, 371–384. [Google Scholar] [CrossRef]
- Ruparelia, J.P.; Chatterjee, A.K.; Duttagupta, S.P.; Mukherji, S. Strain specificity in antimicrobial activity of silver and copper nanoparticles. Acta Biomater. 2008, 4, 707–716. [Google Scholar] [CrossRef] [PubMed]
- Xu, F.F.; Imlay, J.A. Silver (I), mercury (II), cadmium (II), and zinc (II) target exposed enzymic iron-sulfur clusters when they toxify Escherichia coli. Appl. Environ. Microbiol. 2012, 78, 3614–3621. [Google Scholar] [CrossRef] [Green Version]
- Liu, J.; Wang, J.; Yu, X.; Li, L.; Shang, S. One-pot synthesis of polypyrrole/AgCl composite nanotubes and their antibacterial properties. Nano Micro Lett. 2015, 10, 50–53. [Google Scholar] [CrossRef]
- Upadhyay, J.; Kumar, A.; Gogoi, B.; Buragohain, A.K. Antibacterial and hemolysis activity of polypyrrole nanotubes decorated with silver nanoparticles by an in-situ reduction process. Mater. Sci. Eng. C 2015, 54, 8–13. [Google Scholar] [CrossRef]
- Saad, A.; Cabet, E.; Lilienbaum, A.; Hamadi, S.; Abderrabba, M.; Chehimi, M.M. Polypyrrole/Ag/mesoporous silica nanocomposite particles: Design by photopolymerization in aqueous medium and antibacterial activity. J. Taiwan Inst. Chem. Eng. 2017, 80, 1022–1030. [Google Scholar] [CrossRef]
- Salabat, A.; Mirhoseini, F.; Mahdieh, M.; Saydi, H. A novel nanotube-shaped polypyrrole–Pd composite prepared using reverse microemulsion polymerization and its evaluation as an antibacterial agent. New J. Chem. 2015, 39, 4109–4114. [Google Scholar] [CrossRef]
- Kolla, H.S.; Surwade, S.P.; Zhang, X.; MacDiarmid, A.G.; Manohar, S.K. Absolute molecular weight of polyaniline. J. Am. Chem. Soc. 2005, 127, 16770–16771. [Google Scholar] [CrossRef] [PubMed]
- Zhang, L.; Alfano, J.R.; Becker, D.F. Proline metabolism increases katG expression and oxidative stress resistance in Escherichia coli. J. Bacteriol. 2015, 197, 431–440. [Google Scholar] [CrossRef] [PubMed] [Green Version]
- An, X.; Xiong, W.; Yang, Y.; Li, F.; Zhou, X.; Wang, Z.; Deng, Z.; Liang, J. A novel target of IscS in Escherichia coli: Participating in DNA phosphorothioation. PLoS ONE 2012, 7, e51265. [Google Scholar] [CrossRef] [PubMed] [Green Version]
- Hou, Y.; Feng, J.; Wang, Y.; Li, L. Enhanced antibacterial activity of Ag-doped ZnO/polyaniline nanocomposites. Mater. Sci. Mater. Electron. 2016, 27, 6615–6622. [Google Scholar] [CrossRef]
- Mohsen, R.M.; Morsi, S.M.M.; Selim, M.M.; Ghoneim, A.M.; El-Sherif, H.M. Electrical, thermal, morphological, and antibacterial studies of synthesized polyaniline/zinc oxide nanocomposites. Polym. Bull. 2019, 76, 1–21. [Google Scholar] [CrossRef]
- Maruthapandi, M.; Saravanan, A.; Luong, J.H.T.; Gedanken, A. Antimicrobial properties of the polyaniline composites against Pseudomonas aeruginosa and Klebsiella pneumoniae. J. Funct. Biomater. 2020, 11, 59. [Google Scholar] [CrossRef] [PubMed]
- Shaban, M.; Rabia, M.; Fathallah, W.; El-Mawgoud, N.A.; Mahmoud, A.; Hussien, H.; Said, O. Preparation and characterization of polyaniline and ag/ polyaniline composite nanoporous particles and their antimicrobial activities. J. Polym. Environ. 2018, 26, 434–442. [Google Scholar] [CrossRef]
- Ma, C.; Yang, Z.; Wang, W.; Zhang, M.; Hao, X.; Zhu, S.; Chen, S. Fabrication of Ag–Cu2O/PANI nanocomposites for visible-light photocatalysis triggering super antibacterial activity. J. Mater. Chem. C 2020, 8, 2888–2898. [Google Scholar] [CrossRef]
- Boomi, P.; Poorani, G.P.; Palanisamy, S.; Selvam, S.; Ramanathan, G.; Ravikumar, S.; Barabadi, H.; Prabu, H.G.; Jeyakanthan, J.; Saravanan, M. Evaluation of antibacterial and anticancer potential of polyaniline-bimetal nanocomposites synthesized from chemical reduction method. J. Clust. Sci. 2019, 30, 715–726. [Google Scholar] [CrossRef]
- Mirmohseni, A.; Rastgar, M.; Olad, A. Effectiveness of PANI/Cu/TiO2 ternary nanocomposite on antibacterial and antistatic behaviors in polyurethane coatings. J. Appl. Polym. Sci. 2020, 137, 48825. [Google Scholar] [CrossRef]
- Masim, F.C.P.; Tsai, C.H.; Lin, Y.F.; Fu, M.L.; Liu, M.; Kang, F.; Wang, Y.F. Synergistic effect of PANI–ZrO2 composite as antibacterial, anti-corrosion, and phosphate adsorbent material: Synthesis, characterization and applications. Environ. Technol. 2019, 40, 226–238. [Google Scholar] [CrossRef]
- Oves, M.; Ansari, M.O.; Darwesh, R.; Hussian, A.; Alajmi, M.F.; Qari, H.A. Synthesis and antibacterial aspects of graphitic C3N4@polyaniline composites. Coatings 2020, 10, 950. [Google Scholar] [CrossRef]
- Deshmukh, S.P.; Dhodamani, A.G.; Patil, S.M.; Mullani, S.B.; More, K.V.; Delekar, S.D. Interfacially interactive ternary silver-supported polyaniline/multiwalled carbon nanotube nanocomposites for catalytic and antibacterial activity. ACS Omega 2020, 5, 219–227. [Google Scholar] [CrossRef]
- Wang, L.; Hu, C.; Shao, L. The antimicrobial activity of nanoparticles: Present situation and prospects for the future. Int. J. Nanomed. 2017, 12, 1227. [Google Scholar] [CrossRef] [PubMed] [Green Version]
- Ling, D.; Hyeon, T. Chemical design of biocompatible iron oxide nanoparticles for medical applications. Small 2013, 9, 1450–1466. [Google Scholar] [CrossRef] [PubMed]
- Jeng, H.A.; Swanson, J. Toxicity of metal oxide nanoparticles in mammalian cells. J. Environ. Sci. Health Part A 2006, 41, 2699–2711. [Google Scholar] [CrossRef] [PubMed]
- Adamcakova-Dodd, A.; Thorne, P.S.; Grassian, V.H. Handbook of Systems Toxicology; Cascinao, D.A., Sahu, S.C., Eds.; John Wiley: Chichester, UK, 2011; pp. 803–834. [Google Scholar]
- Seil, J.T.; Webster, T.J. Antimicrobial applications of nanotechnology: Methods and literature. Int. J. Nanomed. 2012, 7, 2767–2781. [Google Scholar]
- Yuan, H.; Zhan, Y.; Rowan, A.E.; Xing, C.; Kouwer, P.H.J. Biomimetic networks with enhanced photodynamic antimicrobial activity from conjugated polythiophene/polyisocyanide hybrid hydrogels. Angew. Chem. Int. Ed. 2020, 59, 2720–2724. [Google Scholar] [CrossRef] [PubMed]
- Chen, J.; Andler, S.M.; Goddard, J.M.; Nugen, S.R.; Rotello, V.M. Integrating recognition elements with nanomaterials for bacteria sensing. Chem. Soc. Rev. 2017, 46, 1272–1283. [Google Scholar] [CrossRef] [PubMed]
- Xu, C.; Akakuru, O.U.; Zheng, J.; Wu, A. Applications of iron oxide-based magnetic nanoparticles in the diagnosis and treatment of bacterial infections. Front. Bioeng. Biotechnol. 2019, 7, 141. [Google Scholar] [CrossRef]
- Arakha, M.; Pal, S.; Samantarrai, D.; Panigrahi, T.K.; Mallick, B.C.; Pramanik, K.; Mallick, B.; Jha, S. Antimicrobial activity of iron oxide nanoparticle upon modulation of nanoparticle-bacteria interface. Sci. Rep. 2015, 5, 14813. [Google Scholar] [CrossRef] [Green Version]
- Blanc-Béguin, F.; Nabily, S.; Gieraltowski, J.; Turzo, A. Cytotoxicity and GMI bio-sensor detection of maghemite nanoparticles internalized into cells. J. Magn. Magn. Mater. 2009, 321, 192–197. [Google Scholar] [CrossRef]
- Denisova, T.P.; Simonova, E.V.; Kokorina, L.A.; Maximova, E.N. Changes in morphotype in the population of E.coli in the presence of metal containing nanoparticles. J. Phys. Conf. Ser. 2019, 1389, 012074. [Google Scholar] [CrossRef]
- Qu, J.; Liu, G.; Wang, Y.; Hong, R.R. Preparation of Fe3O4-chitosan nanoparticles used for hyperthermia. Adv. Powder Technol. 2010, 21, 461–467. [Google Scholar] [CrossRef]
- Kurlyandskaya, G.V.; Litvinova, L.S.; Safronov, A.P.; Schupletsova, V.V.; Tyukova, I.S.; Khaziakhmatova, O.G.; Slepchenko, G.B.; Yurova, K.A.; Cherempey, E.G.; Kulesh, N.A.; et al. Water-based suspensions of iron oxide nanoparticles with electrostatic or steric stabilization by chitosan: Fabrication, characterization and biocompatibility. Sensors 2017, 17, 2605. [Google Scholar] [CrossRef] [Green Version]
- Dubova, N.M.; Slepchenko, G.B.; Khlusov, I.A.; Linh, H.C. The study of iron-based nanoparticles stability in biological fluids by stripping voltammetry. Procedia Chem. 2015, 15, 360–364. [Google Scholar] [CrossRef] [Green Version]
- Lin, W.; Xu, K.; Xin, M.; Peng, J.; Chen, M. Hierarchical porous polyaniline–silsesquioxane conjugated hybrids with enhanced electrochemical capacitance. RSC Adv. 2014, 4, 39508–39518. [Google Scholar] [CrossRef]
- Patil, P.T.; Anwane, R.S.; Kondawar, S.B. Development of electrospun polyaniline/ZnO composite nanofibers for LPG sensing. Procedia Mater. Sci. 2015, 10, 195–204. [Google Scholar] [CrossRef] [Green Version]
- Sapurina, I.; Blinova, N.V.; Stejskal, J.; Trchova, M. The oxidation of aniline with silver nitrate to polyaniline-silver composites. Polymer 2009, 50, 50–56. [Google Scholar]
- Reda, S.M.; Al-Ghannam, S.M. Synthesis and electrical properties of polyaniline composite with silver nanoparticles. Adv. Mater. Phys. Chem. 2012, 2, 75–81. [Google Scholar] [CrossRef] [Green Version]
- Ayad, M.; Zaghlol, S. Nanostructured crosslinked polyaniline with high surface area: Synthesis, characterization and adsorption for organic dye. Chem. Eng. J. 2012, 204, 79–86. [Google Scholar] [CrossRef]
- Locock, K.E.S.; Michl, T.D.; Griesser, H.J.; Haeussler, M.; Meagher, L. Structure–activity relationships of guanylated antimicrobial polymethacrylates. Pure Appl. Chem. 2014, 86, 1281–1291. [Google Scholar] [CrossRef]
- Palermo, E.F.; Lienkamp, K.; Gillies, E.R.; Ragogna, P.J. Antibacterial activity of polymers: Discussions on the nature of amphiphilic balance. Angew. Chem. Int. Ed. 2019, 58, 3690–3693. [Google Scholar] [CrossRef]
- Shi, N.; Guo, X.; Jing, H.; Gong, J.; Sun, C.; Yang, K. Antibacterial effect of the conductng polyaniline. J. Mater. Sci. Technol. 2006, 22, 289–290. [Google Scholar]
- Faghihzadeh, F.; Anaya, N.M.; Schifman, L.A.; Oyanedel-Craver, V. Fourier transform infrared spectroscopy to assess molecular-level changes in microorganisms exposed to nanoparticles. Nanotechnol. Environ. Eng. 2016, 1, 1. [Google Scholar] [CrossRef]
- Liu, Y.; Imlay, J.A. Cell death from antibiotics without the involvement of reactive oxygen species. Science 2013, 339, 1210–1213. [Google Scholar] [CrossRef] [PubMed] [Green Version]
- Boucher, H.W.; Talbot, G.H.; Bradley, J.S.; Edwards, J.E.; Gilbert, D.; Rice, L.B.; Scheld, M.; Spellberg, B.; Bartlett, J. Bad bugs, no drugs: No ESKAPE! An update from the Infectious Diseases Society of America. Clin. Infect. Dis. 2009, 48, 1–12. [Google Scholar] [CrossRef] [PubMed] [Green Version]
- Fiaccadori, E.; Antonucci, E.; Morabito, S.; d’Avolio, A.; Maggiore, U.; Regolisti, G. Colistin use in patients with reduced kidney function. Am. J. Kidney Dis. 2016, 68, 296–306. [Google Scholar] [CrossRef] [PubMed]
- Johansen, H.K.; Moskowitz, S.M.; Ciofu, O.; Pressler, T.; Høiby, N. Spread of colistin resistant non-mucoid Pseudomonas aeruginosa among chronically infected Danish cystic fibrosis patients. J. Cyst. Fibros. 2008, 7, 391–397. [Google Scholar] [CrossRef] [PubMed] [Green Version]
- Qureshi, Z.A.; Hittle, L.E.; O’Hara, J.A.; Rivera, J.I.; Syed, A.; Shields, R.K.; Pasculle, A.W.; Ernst, R.K.; Doi, Y. Colistin-resistant Acinetobacter baumannii: Beyond carbapenem resistance. Clin. Infect. Dis. 2015, 60, 1295–1303. [Google Scholar] [CrossRef] [Green Version]
- Siriwardena, T.N.; Stach, M.; Tinguely, R.; Kasraian, S.; Luzzaro, F.; Leib, S.L.; Darbre, T.; Reymond, J.; Endimiani, A. In vitro activity of the novel antimicrobial peptide dendrimer g3kl against multidrug-resistant Acinetobacter baumannii and Pseudomonas aeruginosa. Antimicrob. Agents Chemother. 2015, 59, 7915–7918. [Google Scholar]
- Regiel-Futyra, A.; Kus-Li’skiewicz, M.; Sebastian, V.; Irusta, S.; Arruebo, M.; Stochel, G.; Kyzioł, A. Development of noncytotoxic chitosan–gold nanocomposites as efficient antibacterial materials. ACS Appl. Mater. Interfaces 2015, 7, 1087–1099. [Google Scholar] [CrossRef] [PubMed]
- Lam, L.; Male, K.B.; Chong, J.H.; Leung, A.C.W.; Luong, J.H.T. Applications of functionalized and nanoparticle-modified nanocrystalline cellulose. Trends Biotechnol. 2012, 30, 283–290. [Google Scholar] [CrossRef] [PubMed]
- Mendoza, G.; Regiel-Futyra, A.; Andreu, V.; Sebastián, V.; Kyzioł, A.; Stochel, G.; Arruebo, M. Bactericidal effect of gold–chitosan nanocomposites in coculture models of pathogenic bacteria and human macrophages. ACS Appl. Mater. Interfaces 2017, 9, 17693–17701. [Google Scholar] [CrossRef] [PubMed]
- Yang, X.; Yang, J.; Wang, L.; Ran, B.; Jia, Y.; Zhang, L.; Yang, G.; Shao, H.; Jiang, X. Pharmaceutical intermediate-modified gold nanoparticles: Against multidrug-resistant bacteria and wound-healing application via an electrospun scaffold. ACS Nano 2017, 11, 5737–5745. [Google Scholar] [CrossRef]
- Zhong, Z.; Male, K.B.; Luong, J.H.T. More recent progress in the preparation of Au nanostructures, properties, and applications. Anal. Lett. 2003, 36, 3097–3118. [Google Scholar] [CrossRef]
- Zhang, Y.; Jiang, J.; Chen, Y. Synthesis and antimicrobial activity of polymeric guanidine and biguanidine salts. Polymer 1999, 40, 6189–6198. [Google Scholar] [CrossRef]
- Saczewski, F.; Balewski, Ł. Biological activities of guanidine compounds. Expert Opin. Ther. Pat. 2009, 19, 1417–1448. [Google Scholar] [CrossRef]
- Berlinck, R.G.S.; Burtoloso, A.C.B.; Kossuga, M.H. The chemistry and biology of organic guanidine derivatives. Nat. Prod. Rep. 2005, 22, 919–954. [Google Scholar] [CrossRef]
- Wichterle, O.; Lim, D. Hydrophilic gels for biological use. Nature 1960, 185, 117–118. [Google Scholar] [CrossRef]
- Veiga, A.S.; Schneider, J.P. Antimicrobial hydrogels for the treatment of infection. Biopolymers 2013, 100, 637–644. [Google Scholar] [CrossRef] [PubMed] [Green Version]
- Bonhome-Espinosa, A.B.; Campos, F.; Rodriguez, I.A.; Carriel, V.; Marins, J.A.; Zubarev, A.; Duran, J.D.G.; Lopez-Lopez, M.T. Effect of particle concentration on the microstructural and macromechanical properties of biocompatible magnetic hydrogels. Soft Matter 2017, 13, 2928–2941. [Google Scholar] [CrossRef] [PubMed]
- Blyakhman, F.A.; Sokolov, S.Y.; Safronov, A.P.; Dinislamova, O.A.; Shklyar, T.F.; Zubarev, A.Y.; Kurlyandskaya, G.V. Ferrogels ultrasonography for biomedical applications. Sensors 2019, 19, 3959. [Google Scholar] [CrossRef] [PubMed] [Green Version]
- Li, S.; Dong, S.; Xu, W.; Tu, S.; Yan, L.; Zhao, C.; Ding, J.; Chen, X. Antibacterial Hydrogels. Adv. Sci. 2018, 5, 1700527. [Google Scholar] [CrossRef] [Green Version]
- Korupalli, C.; Kalluru, P.; Nuthalapati, K.; Kuthala, N.; Thangudu, S.; Vankayala, R. Recent advances of polyaniline-based biomaterials for phototherapeutic treatments of tumors and bacterial infections. Bioengineering 2020, 7, 94. [Google Scholar] [CrossRef]

| S. No | Polypyrole Composites | Solvent | Preparation Method | Model Bacteria | MIC | Maximum Inhibition Time (h) | Ref. |
|---|---|---|---|---|---|---|---|
| 1 | PPY@CuO | Ethanol, Water (9:1) | sonochemical | E. coli, S. aureus | 1 mg/mL | 8 | [26] |
| 2 | Fe3O4@PPY NPs | Water | oxidative polymerization | S. aureus, E. coli | 100 μg/mL | 24 | [31] |
| 3 | PPY@maghemite@ silver | Water | oxidative polymerization | S. aureus | 2 mg/mL | 18–24 | [42] |
| 4 | B-PPY/ZnO | Ethanol | Photo- polymerization | E. coli | 0.03 mg/mL | 24 | [43] |
| 5 | PPY@Ag/RGO | Polyvinyl pyrrolidone & ethylene glycol | sonication | E. coli | 0.2 mg/mL | 24 | [47] |
| 6 | Cellulose nanopaper/Chitosan/PPY | Water | polymerization | S. aureus, E. coli | - | 48 | [48] |
| 7 | Chitosan-gelatin/ tannic acid/PPY | Water | polymerization | S. aureus, E. coli | - | 18 | [51] |
| 8 | PPY-gelatin cryogel | Gelatin | polymerization | S. aureus, E. coli | - | 24 | [52] |
| 9 | Macroporous Melamine Sponges with PPY | Poly(N-vinylpyrrolidone) and nanosilica | precipitation polymerization | S. aureus, E. coli | - | 24 | [56] |
| 10 | Ag/PPY | Water | polymerization | E. coli | - | 30 | [57] |
| 11 | ZFCN@PPY | Water | oxidative polymerization | E. coli | 0.5 mg/mL | 24 | [58] |
| 12 | Nanocellulose-PPY | Water | chemical polymerization | B. subtilis, E. coli | - | 24 | [59] |
| 13 | Polystyrene@ (silver–PPY | Water | oxidative polymerization | E. coli, S. aureus | 50 µg/mL | 24 | [60] |
| Composites Name | Metal/Metal Oxides | Method | Model Bacteria | Concentration | ZOI (mm) | Max. Inhibition Time | Ref. | |
|---|---|---|---|---|---|---|---|---|
| MIC | MBC | |||||||
| Ag-doped ZnO/PANI | Ag/ZnO | sonication and stirring | E. coli S. aureus, C. albicans | 10 mg/L 10 mg/L 5 mg/L | 25 mg/L 25 mg/L 10 mg/L | 35.4 37.4 39.8 | 24 h | [76] |
| PANI/ZnO NCs | ZnO | Stirring | E. coli S. aureus | - | - | 13.0 16.0 | - | [77] |
| PANI-CuO PANI-SiO2 PANI-TiO2 | CuO SiO2 TiO2 | Stirring and Sonication | P. aeruginosa | 220 µg/mL | - | - | 6 h 12 h 6 h | [78] |
| K. pneumoniae | 220 µg/mL | - | - | No effect 12 h 6 h | ||||
| Ag/PANI Nanoporous Composite | Ag | Oxidative polymerization under visible light irradiations lamp | E. coli S. aureus B. subtilis Salmonella | - - - - | - - - - | 18.0 22.5 19.0 20.0 | 24 h | [79] |
| Ag-Cu2O/PANI | Ag/Cu2O | Stirring | S. aureus P. aeruginosa | 75 µg/mL 50 µg/mL | - - | - - | 30 days (High long-term ABA) | [80] |
| PANI-Au–Pt Nanocomposites | Au-Pt | Stirring | B. subtilis S. aureus E. coli V. cholerae | 25 µg/mL | 25 µg/mL | 33.0 30.0 26.0 23.0 | 24 h | [81] |
| PANI/Cu/TiO2 | Cu/TiO2 | Stirring | E. coli Salmonella B. cereus S. aureus | - - - - | - - - - | - - - - | 24 h | [82] |
| PANI-ZrO2 composite | ZrO2 | Stirring | E. coli S. aureus | - - | 0.002g/mL 0.001g/mL | 14.0 18.0 | 24 h | [83] |
| PANI@g-C3N4 | g-C3N4 | - | E. coli S. pneumoniae | 60 µg/mL 60 µg/mL | - - | 16.0 18.0 | 24 h | [84] |
| PANI/MWCNT | MWCNT | Stirring | E. coli S. aureus | - - | - - | 20.0 19.0 | [85] | |
Publisher’s Note: MDPI stays neutral with regard to jurisdictional claims in published maps and institutional affiliations. |
© 2022 by the authors. Licensee MDPI, Basel, Switzerland. This article is an open access article distributed under the terms and conditions of the Creative Commons Attribution (CC BY) license (https://creativecommons.org/licenses/by/4.0/).
Share and Cite
Maruthapandi, M.; Saravanan, A.; Gupta, A.; Luong, J.H.T.; Gedanken, A. Antimicrobial Activities of Conducting Polymers and Their Composites. Macromol 2022, 2, 78-99. https://doi.org/10.3390/macromol2010005
Maruthapandi M, Saravanan A, Gupta A, Luong JHT, Gedanken A. Antimicrobial Activities of Conducting Polymers and Their Composites. Macromol. 2022; 2(1):78-99. https://doi.org/10.3390/macromol2010005
Chicago/Turabian StyleMaruthapandi, Moorthy, Arumugam Saravanan, Akanksha Gupta, John H. T. Luong, and Aharon Gedanken. 2022. "Antimicrobial Activities of Conducting Polymers and Their Composites" Macromol 2, no. 1: 78-99. https://doi.org/10.3390/macromol2010005
APA StyleMaruthapandi, M., Saravanan, A., Gupta, A., Luong, J. H. T., & Gedanken, A. (2022). Antimicrobial Activities of Conducting Polymers and Their Composites. Macromol, 2(1), 78-99. https://doi.org/10.3390/macromol2010005

